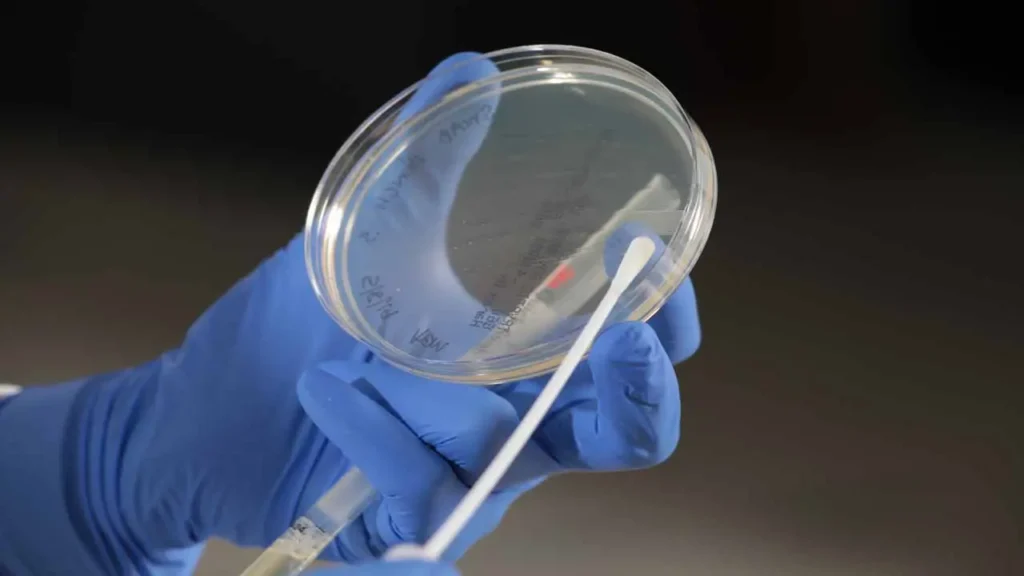

Major marijuana markets still lacking controls for suspicious lab results
More than half of the country’s biggest marijuana markets do not have a reference lab, according to analysis by MJBizDaily, a glaring gap that critics say raises major questions about product labeling and safety.
Major marijuana markets still lacking controls for suspicious lab results is a post from: MJBizDaily: Financial, Legal & Cannabusiness news for cannabis entrepreneurs
